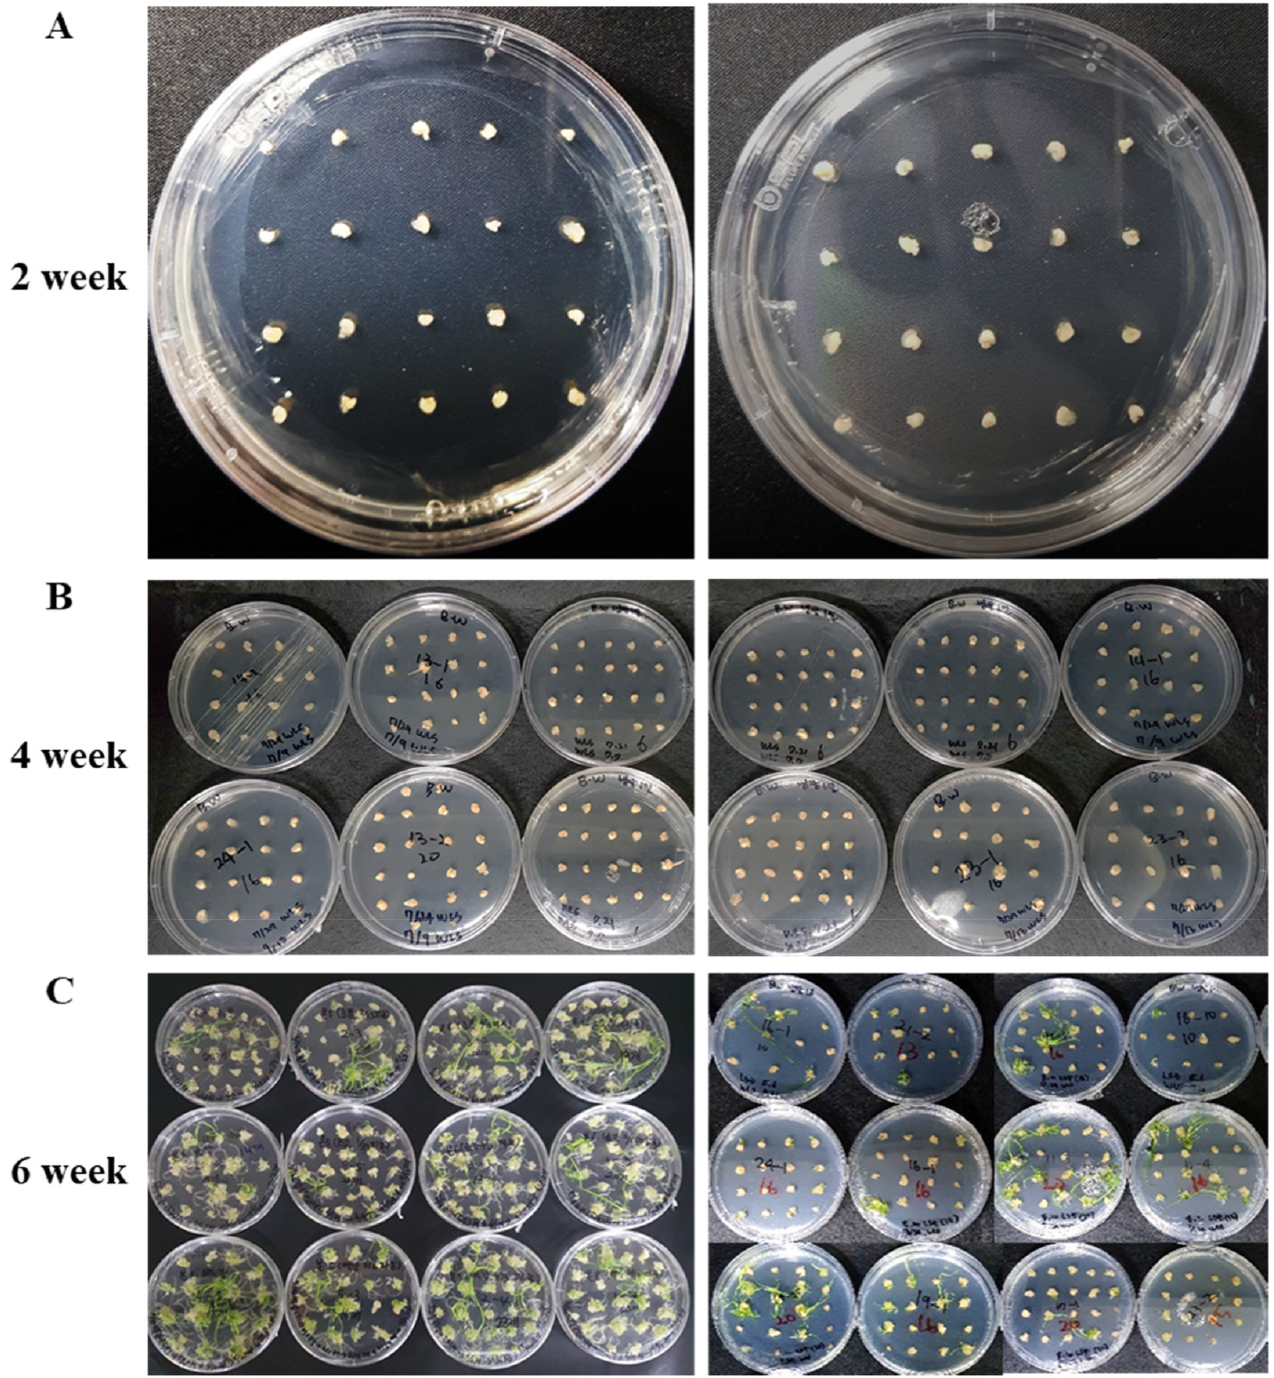
https://cdn.apub.kr/journalsite/sites/kjcs/2020-065-04/N0840650412/images/kjcs_65_04_12_F4.jpg

서 론
재료 및 방법
식물재료 및 재배조건
스피드 브리딩 생장 조건
생육 조사
조직 배양
항산화 효소 활성 분석
유전자 발현분석
통계처리
결과 및 고찰
스피드 브리딩 생육조건의 Bobwhite의 세대 단축 효과
배양조건에 따른 미성숙배 조직배양 효율 검정
배양조건에 따른 항산화 효소 활성 검정
배양조건에 따른 생육 연관유전자의 유전자 발현 검정
적 요
서 론
보통 밀(Triticum aestivum L., AABBDD, 2n = 6x = 42)은 연간 생산량이 7억 9500만톤에 달하는 식량 작물로서 현재 인간에게 제공되는 칼로리 중 35%를 차지하는 주식이다(FAO, 2018; Ali et al., 2020). 국내에서 밀의 1인당 연간소비량은 2019년 기준 34.2 kg이며 이는 주식인 쌀 다음으로 많은 소비가 이루어지고 있다(Statistics Korea, 2019). 밀 소비량은 꾸준하게 늘고 있으나 대부분의 밀은 수입에 의존하고 있다. 2019년 식용 밀 수입량은 240만톤(Korea Customs Service, 2020)을 넘어섰으나 국내 밀 재배면적은 6,600 ha에서 3,736 ha로 급감하면서 생산량은 1만5천톤에 불과하다(Statistics Korea, 2019). 이로 인한 밀 자급률은 최근 3년간 평균 1.5%대로 매우 낮은 실정이다(Kim et al., 2019). 최근 정부에서 안정적인 국산 밀 공급 체계 구축을 위한 2018년 밀 산업 중장기 발전 대책을 내 놓았고, 밀 산업 육성법을 제정하여 2020년 2월 28일 본격적으로 시행됨에 따라 밀의 2022년 목표 자급률을 9.9%로 설정하였다(Kim et al., 2020). 따라서 정부의 정책 취지에 맞추어 국내 밀의 품질 향상과 가공 적성에 맞춘 우수한 국산 밀 품종 개발을 위한 여러 육종 소재 개발이 시급한 과제이다.
보통 밀은 염색체의 크기가 17 Gb로 매우 크고 42개의 염색체와 85%의 반복된 DNA 서열을 포함하는 복잡성으로 인해 신품종을 육성하기 위한 분자 육종 연구에 많은 어려움이 있다(Paux et al., 2006). 최근 작물 육종 기술 중 외부에서 도입된 유전자가 존재하지 않지만 특정 유전 형질이 변형된 특성을 갖게 하여 새로운 품종을 확보하는 기술인 신육종기술(New Plant Breeding Techniques)이 개발되면서 국내의 기존 작물 육종 기술에 접목한 활용에 대해서 많은 검토가 이루어 지고 있다(KISTEP, 2018). 작물 형질전환은 기존의 육종으로는 불가능한 새로운 유전자를 도입할 수 있는 기술로 이용되지만 유전자 변형 기술을 개발하는데 상당한 어려움이 있다(Bhalla et al., 2006). 밀에서의 형질전환은 최초로 1992년 유전자총(particle bombardment)을 이용하여 배발생 캘러스(embryogenic callus)에 제초제(Basta) 저항성 유전자(Bar gene)를 전달하는 실험이 성공적으로 이루어졌다(Vasil et al., 1992). 또한 Agrobactrium-mediated 방법을 이용하여 미성숙배로 유발된 캘러스를 이용하여 nptii (neomycin phosphotransferase II)유전자를 도입하였다(Cheng et al., 1997). 하지만 성공적인 형질전환은 미성숙배 유도 환경에 따라서 무작위로 발생하며 매우 낮은 형질전환 효율을 보인다. Altpeter et al. (1996)에 의하면 7,650개의 배아를 이용하였을 때 0.3%의 효율로 형질전환이 발생하였고 Cheng et al. (1997)의 실험에서는 이용된 조직에 따라서 최저 0.14%에서 최대 2.8%로 매우 낮은 확률로 발생했다. 형질전환 기술은 여러가지 육종 소재를 개발하기 위한 매우 좋은 방법이나 성공률을 높이기 위한 선행 요건 필요하다. 이를 위하여 최적의 미성숙배의 생육 조건과 조직배양의 연속성을 위한 미성숙배의 지속적인 공급이 매우 중요하다.
미성숙배 배양(immature embryogenesis)기술은 높은 재분화(Regeneration)율로 인하여 형질전환의 효율을 높이기 위하여 자주 활용되는 방법 중에 하나이다(Murín et al., 2012). 하지만 밀의 개화 후 일정 기간에만 미성숙배를 수집할 수 있기 때문에 매우 노동집약적이고 많은 시간과 공간이 필요하다(Alikina et al., 2016). 따라서, 안정적이고 대량의 미성숙배 공급이 형질전환 효율을 높이기 위한 중요한 요건 중 하나이다. 최근 Watson et al. (2018)에 의하면 장일식물인 밀의 일장을 22시간으로 늘린 장일 처리를 통한 출수기 단축으로 1년에 6세대까지 세대를 진전시킬 수 있는 스피드육종법이 발표되었다. 국내에서도 국립식량과학원에서 국내 밀 품종 금강, 백강, 조경, 중모2008을 이용하여 출수 소요 일수를 단축시킨 사례가 있다(Cha et al., 2019). 본 연구에서는 Ghosh et al. (2018)과 Watson et al. (2018)의 방법을 참조하여 생육 조절실을 구축하고 22시간으로 일장을 처리시 출수가 촉진된 식물체와 정상 생육조건에서 식물체에서 미성숙배를 이용하여 조직배양 효율을 측정하였다. 본 연구를 통하여 스피드 브리딩으로 재배된 미성숙배의 조직배양 및 밀 형질전환 기술의 도입 가능성을 검토하였으며 이는 밀 분자육종연구에 기여를 할 것으로 기대된다.
재료 및 방법
식물재료 및 재배조건
본 실험에서 사용된 재료는 밀 형질전환에 특화된 품종 Bobwhite (Accession no : SH98-26)를 미국 농림부(USDA- ARS)에서 분양 받아 공주대학교 연구포장에서 2018년 10월부터 2019년 6월까지 증식된 종자를 이용하였다. 수확한 종자는 2개월간 건조시킨 뒤 물에 적신 30.48 cm X 45.72 cm의 Seed Germination Crepe Paper (Saran Hand Made Paper Industry, Damdama, India)를 이용하여 발아시켰다. 발아는 4°C에서 4주간 지속하여 춘화처리의 효과를 제공하였다. 발아된 밀 seedling은 직경 11 cm의 플라스틱 포트에 원예용상토(Cham Grow, Chungcheongnam province, Korea)를 사용하여 1구당 1립씩 옮겨 심었다. 비료는 유기질비료를 사용했으며 유묘기 식물체를 처음 옮겨 심을 때 1구에 1 g씩 분주 했다. 1주일의 안정기 이후 포트는 공주대학교 스마트온실과 국립식량과학원으로 이동하여 각각 생육되었다.
스피드 브리딩 생장 조건
스피드 브리딩은 공주대학교 생장조절실(3.9 m × 2.83 m × 2.8 m)에서 진행되었다. 높이 80 cm의 베드 위에 스피드 브리딩을 위한 식물체를 이동하였다. 포트와 광원까지의 거리는 117 cm 떨어져있으며(Fig. 1A) 사용된 광원은 식물생장LED PLANT 300WB (YUNLIGHTING, Gyeonggi province, Korea)이며 충분한 광조건을 위하여 각 베드 당 LED는 3개씩 설치되었다. 식물생장 LED의 조도(Illuminance)와 광합성 광량 자속 밀도(PPFD, Photosynthetic Photon Flux Density)는 식물의 위치에서 각각 40.68 ± 11 Klux, 1013.77 ± 334 µmol/m-2·s-1으로 조절되었다(Fig. 1). 식물 생육 조절실의 일장 조건은 Watson et al. (2018)를 참고하여 24시간 중 일장을 22시간으로 늘리고 2시간 소등으로 설정하였다. 생장조절실의 온도는 수냉식냉방기 HWC-2470 (AIRREX, Gyeonggi province, Korea)을 이용하여 22°C로 설정하였다. 정상 생육은 국립식량과학원 온실에서 진행되었으며 Kim et al. (2014)의 방법을 이용하여 약간의 변경을 적용하여 수행하였다. 높이 20 cm 파렛트 위에 식물이 위치하여 추가적인 광원없이 태양광을 이용하였다. 온실 내부의 온도는 냉방시설 없이 환기를 통하여 각 파종 시기의 생장 기간의 기후에 맞게 조절되었다. 동절기의 급격한 기온 하강을 막기위해 야간에 양옆의 비닐 및 출입문을 닫아 기온을 조절하였다.

Fig. 1
Information on the benchtop made with the iron frame and the light source using LEDs in the controlled growth room. (A) Schematic diagram of the bench in the controlled growth room. The pots were placed at 117 cm distances from the light fixture. (B)-(C) The light spectrum condition of the LED (YUNLIGHTING, Republic of Korea) used in the controlled growth room was different from that described in Sreya et al. (2018). (D)-(E) The Photosynthetic Photon Flux Density (PPFD) and illuminance of the LED. (F) Temperature profiles from the sowing date to the flowering date.
생육 조사
생육조사는 농촌진흥청 농업과학기술 연구조사분석기준(RDA, 2012)에 따라 수행되었다. 출수기는 동일 파종 포트의 40%가 잎집에서 이삭이 2/3이상 나왔을 때로 출수 일수는 파종일부터 출수기까지의 일수로 계산하였다. 개화기는 소수에서 수술이 나왔을 때를 기준으로 하여 각 분얼마다 조사하였고 동일 파종일의 포트에서 40% 이상이 개화 하였을 때로 개화 일수(Days to flowering)은 파종일부터 개화일까지의 일수로 계산하였다.
조직 배양
미성숙배의 배양은 미숙 배의 크기가 직경 1.0~1.5 mm가 되었을 때 수행하였으며 일반적으로 개화 후 11일이 되었을 때의 이삭을 이용하였다. 수확한 이삭의 내영과 외영이 제거된 영과(caryopsis)를 분리하여 종자 소독을 실시하였다. 종자 소독은 50 ml conical tube (SPL, Gyeonggi province, Korea)에 담아서 Hayta et al. (2019)의 방법을 따라 70% 에틸알코올과 10% 차아염소산나트륨용액을 이용하여 수행하였다. 소독 된 종자는 멸균수를 이용하여 알코올과 차아염소산나트륨를 제거한 후 클린벤치에서 첨예 형태의 의료용 메스 11호(Feather Safety Razor, Osaka province, Japan)를 이용하여 미성숙 배를 분리하였고 캘러스 유도 배지(WLS, Ishida et al., 2014)에 petri dish 1개당 20개씩 치상하여 25°C에서 암조건으로 캘러스를 유도하였다. 치상 후 2주마다 동일 성분의 배지로 계대배양을 수행하였으며, 미성숙배 배양 4주 후에 생성된 캘러스를 재분화 배지(LSZ, Ishida et al., 2014)로 옮겨 25°C에서 광조건으로 재분화를 유도하였다.
항산화 효소 활성 분석
전체 단백질 추출 과정은 Yoon et al. (2019)를 참고하여 진행하였다. 두 조건에서 개화 후 14일 시기의 이삭에서 분석하였으며 수집된 이삭은 액체 질소를 이용하여 막자사발로 마쇄하였고 2 ml 튜브(Eppendorf AG, Hambur, Germany)에 곱게 갈린 이삭 샘플(100 mg)을 옮겨 담은 후 단백질 추출 용액 [0.2 M phosphate buffer (pH 7.0), 0.1 mM EDTA]을 0.5 ml씩 분주하여 균질하여 혼합하였다. 효율적인 단백질 추축을 위하여 추출버퍼에 혼합된 이삭 샘플을 얼음에서 5분간 배양시킨 한 후, 원심분리기에서 13,000 rpm으로 4°C에서 20분간 원심분리 후 상등액을 1.5 ml 튜브(Eppendorf AG, Hamburg province, Germany)에 옮겨 담아 항산화 효소 활성 분석에 이용하였다. 총 단백질 함량은 Bradford 분석(Bradford, 1976)을 이용하여 확인하였으며 이후 Kim et al.(2015)에 서술된 방법으로 superoxide dismutase (SOD), peroxidase (POD), catalase (CAT), ascorbate peroxidase (APX)단백질의 활성을 측정하였다.
유전자 발현분석
Total RNA는 두 조건에서 개화 후 11일 된 이삭을 수집하여 액체 질소로 급속 냉각 후에 막자사발을 이용하여 마쇄한 샘플을 100 mg으로 정량하였다. 이후 RibospinTM Seed/ Fruit kit (GeneAll, Gyeonggi province, Korea)를 사용하여 제조사에서 제시한 실험방법에 따라 추출하였다. 추출된total RNA의 1 µg을 PrimeScript™ 1st strand cDNA Synthesis Kit (Takara, Tokyo province, Japan)를 이용하여 제조사의 프로토콜에 따라 cDNA를 합성하였다.
정상의 배양조건과 스피드 브리딩 간의 전사체 비교를 위하여 광합성 및 세포분열에 대한 연관유전자를 이용하여 유전자 발현을 검정하였다. 사용된 유전자는 Photosystem I P700 chlorophyll a apoprotein A1 (PsaA, TraesCS3B02 G185500.1, Ensembl Plants), Photosystem II protein D1 (PsbA, TraesCS1D02G179900.1, Ensembl Plants), Cell division control protein (CDC, TraesCS4D02G267800.1, Ensembl Plants)이며, Ensembl Plants의 염기서열 정보를 이용하여 각 유전자에 대한 프라이머로 PsaA (sense primer : 5’-GCAG TAGGTGGCAAAGTGGC-3’, antisense primer : 5’-CTTT CCTTGCGATGGGCCTG-3’), PsbA (sense primer : 5’- GGCGGTTCCCTATTCAGTGC-3’, antisense primer : 5’- CAGGCCAAGCAGCCAAGAAG-3’), CDC (sense primer : 5’-CGAGAAGGACATCGAGAGGG-3’, antisense primer : 5’-CTGGTACTTGCGGATGTCGG-3’)와 같이 디자인하였다. 유전자 발현의 normalization을 위한 reference gene으로 Actin 유전자를 이용되었으며, 사용된 염기서열은 sense primer : 5’- GCTGTTCCAGCCATCTCATGT-3’, antisense primer : 5’- CGATCAGCAATTCCAGGAAAC-3’이다(Liu et al., 2012).
합성된 cDNA는 Rotor gene-Q (Qiagen, Hilden, Germany)를 이용하여 gene-specific primer set로 quantitative RT-PCR을 수행하였다. RT-PCR 수행조건은 two-step 과정으로 95°C에서 5분간 변성 과정(denature step)후, 45 cycle (95°C 10초, 60°C 20초)을 진행하고 melting curve를 65°C에서 95°C까지 진행하여 상대적 발현을 확인하였다. 또한2-ΔΔCt method (Livak et al., 2001)를 이용하여 각 유전자의 상대적 발현 값을 확인하였다. 모든 PCR 분석은 각 유전자 마다 세 번의 반복 수행을 하였고 Actin을 대조군으로 하여 발현 패턴을 분석하였다.
통계처리
조직배양에서 발생한 모든 캘러스와 재분화된 소식물체(plantlet)를 각 단계 별로 조사하여 정상생육 미성숙배와 스피드 브리딩 생육 미성숙배에서 유도된 캘러스 비율, 재분화율을 측정하였다. 측정된 결과는 F-검정(F-value)를 통한 분산 검정 후 t-검정(t-test)를 이용하여 두 집단 간의 평균의 차이에 대한 유의성을 검정하였고, Microsoft Excel 프로그램(Microsoft Corporation, WA, USA)의 data analysis 기능을 이용하였다.
결과 및 고찰
스피드 브리딩 생육조건의 Bobwhite의 세대 단축 효과
선행 보고된 스피드 브리딩(Watson et al., 2018)의 생육 조건과 공주대학교 스마트온실에 구축된 생장조절실의 생육 조건을 비교하기 위하여 광원의 조도와 광합성 광량 자속 밀도를 측정하였다(Fig. 1). 기존의 스피드 브리딩은 광합성 광량 자속 밀도는 최대 450-500 µmol/m-2·s-1를 기준으로 약간 낮거나 높은 수치로 구축되었을 경우 동일한 생육이 유지되었다(Ghosh et al., 2018). 공개된 광량 자속 밀도는 PPFD to Lux Calculator (Waveform lighting, Vancouver, WA, USA)를 이용하여 Lux값을 예측한 결과 17.52~19.46 Klux로 계산되었다. 기존의 스피드 브리딩 연구(Cha et al., 2020; Ghosh et al., 2018; Watson et al., 2018)는 유리온실에서 태양광을 이용하였으며 부족한 일장을 보충하기 위하여 일몰 후 보조광원으로 LED를 이용하였다. 그러나 본 연구에서 사용된 스피드 브리딩 생육 조건은 밀폐된 생장조절실에서 LED등을 이용하여 극단적인 장일 조건(22 h)으로 밀을 생육 하도록 구축되었다. 생장조절실의 밀 생육을 위한 광조건은 LED 광원에서 포트까지의 거리를 계산하여 PPFD 값이 1013.77 µmol/m-2·s-1가 되도록 조절하였으나 실제로 측정된 PPFD와 조도 값은 포트 높이에서 각각 678.78±42 µmol/m-2·s-1, 29.43±1.2 Klux였다. 그러나 출수된 밀 이삭 높이에서는 각각 1,431.21±36 µmol/m-2·s-1, 52.55±1.1 Klux으로 측정되었다(Fig. 1D, E). 또한 광원의 파장은 기존의 스피드 브리딩 조건에서 440~460 nm의 청색광과 580~620 nm의 적색광이 높았지만 본 실험에 사용된 광원은 파장은 420 nm, 450 nm의 청색광 및 670 nm의 적색광이 높게 나타났다(Fig. 1B, C). 이전 연구에 따르면 유리온실에서 측정된 광합성 광량 자속 밀도는 온실에 비추는 태양광의 각도에 따라 약 700~1,300 µmol/m-2·s-1로 측정되었으며(Kadowaki et al., 2012), 이때의 예측 조도 값은 약 27.25~50.61 Klux였다. 생장조절실의 광원은 유리온실에서 측정된 PPFD의 수치와 오차범위 내로 차이가 없었으며 조도 값은 각각 29.43~52.55 Klux와 27.25~50.61 Klux로 측정되어 본 연구에서 활용된 스피드 브리딩의 조도는 자연광을 이용한 스피드 브리딩과 유사하게 나타났다. 따라서 LED만을 이용한 광조건 제공은 유리온실과 광질(light quality)에서 차이가 없음을 확인하였다. 기존의 스피드 브리딩 조건에서 온도 조건은 주간 22°C 야간 17°C로 조절되었다. 생장조절실에서의 온도 조건은 냉방기를 25°C로 설정하여 조절하였으며 실제 측정 온도는 일출 전(04~06시) 평균 19.68°C로 가장 낮았고 주간에는 평균 23.63°C이었으며 생육 기간 동안 월평균 23.63°C로 측정되었다(Fig. 1F). 따라서 스마트온실내 구축된 생장조절실의 생육 조건은 스피드 브리딩 조건과 비교하여 세대 단축 연구에 적합하다고 사료된다.
스피드 브리딩 조건에서 생육 된 Bobwhite를 춘화처리하여 파종하고 생육 조사를 하였다(Fig. 2). 4주간 진행된 춘화처리로 1엽이 나온 상태에서 파종되었다. 스피드 브리딩 조건과 온실에서 성장한 Bobwhite는 3엽기까지 서로 유사한 생육 성장 속도를 나타내었다(Fig. 2A, 2B, 2C). 파종 후 15일 후, 스피드 브리딩 조건에서 분얼기가 시작되었지만 온실 생육조건에서는 4엽기에 그쳤으며(Fig. 2D) 파종 후 19일, 스피드 브리딩 조건에서는 유수형성기와 절간 신장기로 전환되어 간장과 바이오매스의 성장이 온실 생육조건보다 월등히 높게 나타났다(Fig. 2E). 파종 후 28일 후, 스피드 브리딩 조건에서 대부분의 분얼이 절간 신장을 끝내고 지엽이 나타나기 시작하였으나 온실조건에서는 절간신장기에 들어가기 시작한 것으로 확인되었고(Fig. 2F), 스피드 브리딩 조건에서는 파종 후 31일째 처음 출수 하였다(Fig. 2G). Watson et al. (2018)에 의하면 품종에 따라 정상 조건과 비교하여 최소 17일에서 최대 43일까지 출수를 단축시켰으며 출수 소요 일은 30~57일이었다. 본 실험에서 사용된 온실 조건의 Bobwhite는 파종 일에 따라 출수기는 67~91일로 다양했고 스피드 브리딩으로 생육된 Bobwhite의 출수 소요 일은 31~37일로 조사되었다(Table 1). 파종일 별 출수기 차이는 계절의 변화에 따른 기온 상승에 의해서 Bobwhite의 성장 속도에 영향을 미쳤을 것으로 보인다. Bobwhite를 스피드 브리딩에 이용하여 출수를 촉진시킨 연구 사례가 보고된 적은 없으나, 기존에 보고된 6배체 봄밀(Spring wheat)의 세대 단축 효과와 비교하였을 때 세대 단축 효과는 34~37일로 비슷한 수준이었다(Cha et al., 2020, Watson et al., 2018). 본 결과를 통하여 밀 형질전환 특화 품종인 Bobwhite의 스피드 브리딩 생육 조건에서 광 조건 및 온도 조건 조절 따른 세대 단축 효과를 이용하여 출수기를 조절 할 수 있을 것으로 보인다.

Fig. 2
Relative appearance of Bobwhite grown under natural and Speed Breeding conditions on the same days after sowing. The left panel corresponds to the Speed Breeding condition and the right panel to the natural condition. (A) The 4th day after sowing. (B) The 9th day. (C) The 15th day. (D) The 19th day. (E) The 28th day. (F) The 31st day after sowing and the heading stage in the Speed Breeding condition.
Table 1.
Summary of dates for each growth stage under Speed Breeding and natural conditions.
배양조건에 따른 미성숙배 조직배양 효율 검정
Bobwhite의 개화기를 조사하기 위해 각 이삭마다 수술이 나온 날을 확인하여 이름표를 달아 이삭 전체의 개화일을 종합하였다. 각 파종일 별 개화일은 출수 후 3일로 스피드 브리딩 조건과 정상조건에서 모두 동일하였다(Table 1). 개화 후 생육 촉진된 이삭의 발달과정을 정상 생육과 비교하기 위하여, 개화 후 5일부터 하루 간격으로 영과를 수집하여 크기와 미성숙배의 크기를 조사하였다. 발달중인 영과의 길이는 개화 후 5일에서 4 mm였으며 11일에서는 6.5 mm였다(Fig. 3A). 인도의 밀 보리 연구소(ICAR-IIWBR, Indian institute of wheat and barley research)에 의하면 인도에서 상업적으로 이용하는 6배체 밀 품종의 개화 후 6일된 영과는 약 4 mm이며 11일 뒤에는 약 6 mm였다(Yadav et al., 2020). 또한 중국의 리샤허 농업연구소(Lixiahe agricultural science institute, Jiangsu province)에 의하면 중국 밀 품종 Yangmai15의 개화 후 5일된 영과는 약 4.2 mm, 10일 후에는 약 7.25 mm였다(Yu et al., 2020). 스피드 브리딩 조건에서 성장한 Bobwhite의 출수 후 영과 발달 과정은 기존의 정상 조건의 생육 연구와 비교하였을 때 영과의 외관적 특성에서 차이가 나타나지 않았다. 스피드 브리딩 조건에서 성장한 Bobwhite 미성숙배의 크기는 배축을 기준으로 개화 후 9일에 직경 0.8 mm이고 11일에 1.0~1.2 mm로 측정되었다(Fig. 3B). 보통밀의 미성숙배를 이용한 이전의 조직배양 연구에 의하면 재분화 효율을 높이기 위하여 미성숙배의 직경이 1~2 mm 사이의 것을 이용하였지만 밀 품종과 생육 조건에 따라서 미성숙배 분리에 이용된 이삭의 수집시기는 개화 후 11~18일 사이로 다양하였다(Alikina et al., 2016; Gils et al., 2012; Hayta et al., 2019; Tao et al., 2011). 따라서 스피드 브리딩 조건에서 성장한 Bobwhite의 이삭 수집 시기를 미성숙배의 크기가 직경 1~1.5 mm 사이로 균일하게 측정된 개화 후 11일된 이삭을 수집하여 이용하였다(Fig. 3C).

Fig. 3
Immature seed and embryo sizes according to the number of days after flowering under Speed Breeding conditions placed on callus induction medium. (A) The caryopsis collected from the 5th to the 11th day after flowering. (B) Comparison of the size of immature embryos on the 5th and 11th days after flowering. (C) Cultured immature embryos 1-1.5 mm in size on callus induction medium.
조직배양 효율을 검정하기 위해 개화 후 11일 된 영과로부터 미성숙배를 채취하여 캘러스를 유도하였다(Fig. 4). 치상한 미성숙배는 크기에 상관없이 모두 캘러스가 유도 되었으나(Fig. 4A, 4B), 시각을 이용한 관능적 평가에서 배발생 캘러스(embryogenic callus)와 재분화 하지 않는 캘러스(amorphous callus)를 구분할 수 없어 재분화의 여부를 통하여 두 조건에서 채취한 미성숙배의 조직배양 효율을 검정하였다(Alikina et al., 2016). 추가적으로 동일 캘러스에서 배발생 캘러스의 발생 빈도를 측정하기 위하여 재분화한 소식물체(plantlet, Fig. 4C)의 개수를 취합하여 캘러스와의 비율을 계산하였다. 정상조건에서는 개화기가 다른 샘플을 이용하여 6번의 반복실험을 진행하였고, 스피드 브리딩 조건에서는 14번의 반복 실험이 이루어졌다(Table 2). 반복실험 별 재분화율은 정상조건과 스피드 브리딩 조건 모두 최소 14%에서 최대 81%로 큰 차이를 보였으나 조건 별 재분화율의 평균은 각각 45.05%와 43.18%로 나타났다. 두 조건에서 치상 된 미성숙배 개수의 합은 각각 455, 686개이고 캘러스 당 발생한 슈트의 비율의 평균은 각각 1.47, 1.68로 나타났다(Table 2, Fig. 5). 두 집단간의 재분화율과 캘러스에 발생한 슈트 비율에 유의한 차이가 있는지 통계적으로 검정하기 위해 t-test를 진행하였다. 그 결과 정상조건과 스피드 브리딩 조건에서 생육한 Bobwhite에서 수집한 미성숙배의 재분화율 및 배발생 캘러스의 발생 빈도는 통계적으로 유의한 차이가 발견되지 않았으며 두 결과 모두 표준 오차 안의 값을 나타냈다(Table 2, Fig. 5). 이를 통하여 고도의 장일 조건에 의하여 세대 촉진된 Bobwhite를 이용한 미성숙배 조직배양의 효율은 정상조건과 비교 하였을 때 차이가 없는 것으로 나타났다.
Fig. 4
The Callus induction and regeneration process of immature embryos collected under each condition. The left panel shows calli and plantlets from the natural conditions, and the right panel shows those from the Speed Breeding condition. (A) Two weeks after being placed on the callus induction medium. (B) Two weeks after transfer to the same medium. (C) Two weeks after transfer to the regeneration medium.
Table 2.
Calli induction and plant regeneration from excised immature embryos under Speed Breeding and greenhouse conditions.
| Condition | Event |
No. of Cultured embryos |
Callus Induction (%)1) |
Regeneration Efficiency (%)2) |
Ratio of regenerated shoots3) |
|
Control (green house) | Event1 | 73 | 100 | 20.55 | 1.37 |
| Event2 | 131 | 100 | 56.49 | 0.76 | |
| Event3 | 86 | 100 | 73.26 | 1.16 | |
| Event4 | 50 | 100 | 50.00 | 2.00 | |
| Event5 | 65 | 100 | 20.00 | 1.54 | |
| Event6 | 50 | 100 | 50.00 | 2.00 | |
| Total | 455 | Mean | 45.05a | 1.47b | |
|
Speed Breeding | Event1 | 77 | 100 | 79.22 | 1.66 |
| Event2 | 50 | 100 | 38.00 | 1.53 | |
| Event3 | 37 | 100 | 81.08 | 1.97 | |
| Event4 | 42 | 100 | 76.19 | 1.91 | |
| Event5 | 50 | 100 | 28.00 | 1.64 | |
| Event6 | 50 | 100 | 44.00 | 1.64 | |
| Event7 | 50 | 100 | 20.00 | 2.00 | |
| Event8 | 50 | 100 | 52.00 | 1.31 | |
| Event9 | 30 | 100 | 60.00 | 1.78 | |
| Event10 | 50 | 100 | 14.00 | 2.57 | |
| Event11 | 50 | 100 | 26.00 | 2.00 | |
| Event12 | 50 | 100 | 28.00 | 1.21 | |
| Event13 | 50 | 100 | 36.00 | 1.22 | |
| Event14 | 50 | 100 | 22.00 | 1.09 | |
| Total | 686 | Mean | 43.18a | 1.68b |
배양조건에 따른 항산화 효소 활성 검정
고도의 장일 조건으로 인하여 출수가 촉진된 Bobwhite의 산화 스트레스 여부를 검정하기 위해 개화 후 14일 된 이삭의 총 단백질을 추출하여 항산화 효소 활성을 검정하였다(Fig. 6). 항산화 효소 APX, SOD, CAT, POD의 활성은 정상 조건과 출수가 촉진된 이삭에서 비슷한 경향을 보였다. 정상조건과 장일조건에서 수집된 이삭의 APX 활성도는 각각 338.81, 361.05 U mg-1 protein 이고 차례로 SOD는 12.67, 14.10 U mg-1 protein, CAT는 7.07, 7.19 U mg-1 protein, POD는 36.62, 37.79 U mg-1 protein였다. APX와 SOD는 그래프 상에서 약간의 차이를 보였으며 두 가지 모두 장일조건에서 약간 높은 값을 나타냈다(Fig. 5A, B). 하지만 APX, SOD, CAT, POD 모두 표준오차의 범위 안의 값을 나타내어 유의한 차이는 나타나지 않았다(Fig. 6). 식물의 성장과정에서 활성산소(Reactive oxygen species, ROS)의 생성은 APX, SOD, CAT, POD와 같은 항산화 효소로 인해서 농도를 체계적으로 조절한다(Kim et al., 2015). 그러나 비생물적 스트레스나 병원체의 감염으로 인해 고농도 활성산소의 생성은 항산화 균형을 잃게 하여 세포 수준에서의 점진적인 산화반응이 세포 구성 요소의 손상을 악화시킨다(Hasanuzzaman et al., 2011; Sharma et al., 2012; Zhu et al., 2010). 벼의 묘목에서 NaCl 처리로 스트레스를 유발한 항산화 효소 활성 연구에 의하면, SOD, CAT, POD 모두 지속적인 염 스트레스로 인하여 항산화 효소의 활성도가 올라갔다(Sun et al., 2020). 또한 알칼리성 스트레스를 받은 벼 뿌리에서 활성산소(ROS)가 과도하게 축적되어 그 농도가 현저하게 늘어났고, 이에 대한 식물의 항산화 메커니즘이 활성화되어 알칼리성 스트레스에서 과도하게 발생한 활성산소를 제거하기위한 항산화 효소 SOD, POD, CAT, APX의 발현이 증가했다(Zhang et al., 2017). 본 실험에서의 고도의 장일조건에 의해서 출수가 촉진된 개화 후 14일 된 Bobwhite 이삭에서 수행한 항산화 효소 APX, SOD, CAT, POD의 활성도 측정에서 나타난 수치는 APX와 SOD에서 약간의 수치 증가가 있었지만 모두 표준오차 이내의 결과였으며, CAT와 POD에서는 항산화 효소 활성에 관한 선행 연구에서 나타난 수치 변화와 같은 유의한 차이가 보여지지 않았으므로 정상조건과 비교하였을 때 스트레스 반응을 하지 않았다고 판단하였다.
배양조건에 따른 생육 연관유전자의 유전자 발현 검정
정상생육과 스피드 브리딩의 일장 조건의 차이에 따른 유전자 발현 차이를 검정하기 위하여 광합성 연관 유전자 2종(PsaA, PsbA)과 세포분열 연관 유전자 1종(CDC)에 대하여 qRT-PCR을 수행하였다. 정상조건과의 발현차이를 보기 위해 개화 후 11일 된 이삭을 수집하여 RNA를 추출 후 qRT-PCR를 수행하였다(Fig. 7). PsaA 유전자는 정상조건에 비하여 스피드 브리딩 조건에서 급격하게 발현이 증가하였으나 PsbA는 정상조건과 스피드 브리딩 조건 사이에 차이가 없었다(Fig. 7A, 7B). PsaA와 PsbA는 엽록체 내에서 각각 광계 I과 광계 II를 구성하는 주요한 소단위체(subunit)의 하나로 알려져 있다(Sultana et al., 2020, Ozakca, 2013). 식물의 광합성은 온도, 자외선, 일사량, 가뭄 및 염분과 같은 환경요인이 영향을 미치는 것으로 알려져 있으며, 광계 I은 엽록체에서 활성산소의 생성과 소거를 주도하는 주요 위치이지만 환경조건에 의해 발생한 산화스트레스(Oxidative stress)는 활성산소로 인한 광계 I의 광억제(photoinhibition)현상을 일으킨다(Jones et al., 1966; Ogawa et al., 1995; Teroshima et al., 1994). PsaA는 광계 I의 핵심단백질(core protein)으로서 광계 I의 집합체 형성에 관여하게 되며 광계 I의 안정성을 유지하게 한다(Leelavathi et al., 2011). 광계 II의 D1 단백질은 PsbA에 의해서 암호화 되며 빛 에너지를 이용하여 물 분자의 산화 반응 촉매를 담당하는 단백질이며, 특히 다양한 환경 스트레스에 대한 민감성에 관한 역할을 한다(Pandey et al., 2008). 높은 조도와 산화스트레스는 광계 II에 심각한 손상을 일으키며, 광계가 복구될 때 손상된 D1 단백질의 교체(turnover)가 활발히 이루어진다(Henmi et al., 2003; Jin et al., 2018). 본 실험에서 PsaA의 발현이 스피드 브리딩 조건에서 현저하게 증가한 것은 극도의 장일 조건으로 인한 산화스트레스를 억제하기 위한 것으로 예상된다. PsaA는 활성산소 제거(ROS Scavenging)메커니즘에 관여하는 것으로 알려져 있다(Leelavathi et al., 2011). PsaA의 발현 증가(Fig. 7A)는 스피드 브리딩 조건의 이삭의 활성산소를 효율적으로 제거하여 안정적인 광합성률을 유지시키기 때문에 항산화효소의 활성분석에서 차이가 없는 것을 유도하게 되었다고 추측한다(Fig. 6).

Fig. 7
Expression profiles of reference genes for photosynthesis and cell division by qRT-PCR in spikes collected under each condition. (A) Expression analysis of the PsaA gene. (B) Expression analysis of PsbA. (C) Expression analysis of CDC. Each expression was normalized to the expression of the actin gene using the delta delta ct method.
PsbA의 발현 차이가 보이지 않은 것(Fig. 7B)은 극도의 장일조건과 산화스트레스에 의한 광계 II의 손상된 D1 단백질의 교체에서 차이가 나타나지 않기 때문이다. Leelavathi et al. (2011)에 의하면 PsbB도 활성산소 제거에 관여한다고 보고되어 있으나 스피드 브리딩에서는 PsaA가 우선적으로 발현되는 것으로 검정되었다.
CDC 유전자의 발현은 정상조건에 비하여 스피드 브리딩 조건에서 발현이 높게 나타났다(Fig. 7C). 밀의 CDC 유전자는 microarray를 통하여 처음 보고되었으며 도메인 분석을 통하여 cell division control protein (ATPases의 AAA- superfamily)으로 분류되었고 다양한 조건의 발현분석을 통해 세포분열과 직적접 연관되는 유전자로 확인되었다(Garrido et al., 2020; Gimenez et al., 2010; Paolacci et al., 2009). ATPases는 모든 생물체에서 ATP가 가수분해 되어 추출된 에너지가 단백질 합성과 분해, DNA 재조합, 복제 및 복구와 분자적 생리 활동에 관여하며(Snider et al., 2008), CDC48 유전자는 세포 분열과 세포 성장 과정에 연관되어 분열하는 조직에서 우선적으로 발현된다고 보고되었다(Begue et al., 2019). 따라서, 스피드 브리딩 조건에서 성장한 Bobwhite는 정상조건에 비해 빠른 생장을 가지고 있으며 그로인해 세포 분열의 효율이 증가하여 CDC의 발현이 증가한 것으로 사료된다.
본 연구는 극단적 장일 조건을 유도하여 밀의 출수를 촉진시키는 스피드 브리딩을 적용한 실험으로 스피드 브리딩 조건에서 형성된 미성숙배의 조직배양 효율이 정상조건 비해서 차이가 없음을 증명하였다. 또한 항산화 효소 활성 분석 및 연관된 표지 유전자 발현 검정을 통하여 스피드 브리딩 조건에서 생육된 밀 이삭의 활용이 가능하다는 것을 간접적으로 증명하였다. 이 결과는 밀 조직배양 및 형질전환 기술에 활용될 것으로 기대한다.
적 요
미성숙배를 이용한 조직배양은 높은 재분화율로 인하여 밀 형질전환에 적용하기 위한 가장 좋은 방법이지만 매우 한정적인 수집시기와 생육조건으로 인해 이용하기 위한 시간의 제한과 많은 노동력이 집약되어있다. 따라서 안정적이고 지속적인 미성숙배 수집을 위해 스피드 브리딩 조건을 이용하여 출수가 촉진된 밀 이삭을 이용한 미성숙배 조직배양의 효율을 검정하였고, 연구결과는 다음과 같다.
1. 스피드 브리딩 조건의 출수기는 정상조건과 비교하여 36일에서 54일까지 단축되었으며, 개화 후 11일 된 영과에서 수집된 미성숙배 조직배양의 재분화율과 소식물체 출현 비율은 정상조건과 비교하여 유의한 차이가 없다는 것을 확인하였다.
2. 두 배양 조건에서 항산화 효소 활성 분석 결과 차이가 나타나지 않았으며, 연관 표지 유전자 발현 검정을 통하여 일장과 세포분열과의 관계를 검정하여 스피드 브리딩 조건에서 수집된 이삭의 안정성을 검정하였다.
3. 본 연구 결과는 스피드 브리딩 조건을 활용한 미성숙배 조직배양에 활용될 것이며 관련 유전자 발현 및 항산화활성 검정 결과를 통해 검증된 안정적 미성숙배는 밀 형질전환 기술 개발에 활용될 수 있을 것으로 사료된다.






